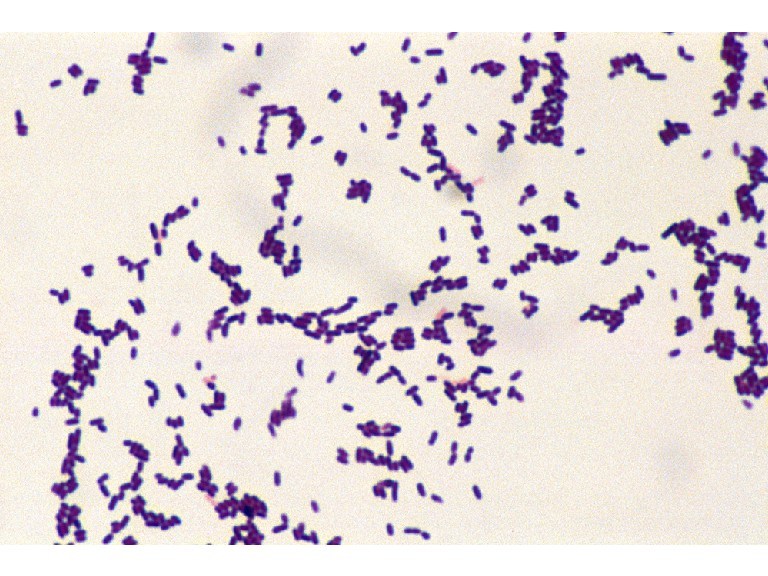

Другие названия и синонимы
Listeriosis.
МКБ-10 коды
- МКБ-10
- A32 Листериоз
|
|
Описание
Листериоз является заболеванием, которое вызывается особыми бактериями - листериями. Это инфекционное заболевание развивается после употребления зараженной пищи. Микробы могут распространиться по кровотоку к центральной нервной системе. У женщин, которые болеют листериозом во время беременности, заболевание часто вызывает выкидыш или мертворождение.
Листерии могут паразитировать в животных и птицах, они так же найдены в почве, воде, канализации, а также в корме для животных. У 5 из 100 обследуемых людей в кишечнике выявляют листерий. Листериоз считается болезнью пищевого происхождения, потому что большинство людей, вероятно, заражаются после приема пищи, обсемененной листериями. Тем не менее, женщина может передать бактерии ребенку во время беременности. Кроме того, было несколько случаев, когда работники соответствующих профессий заражались листериозом, касаясь инфицированных телят и птицы.
Лица с особым риском по листериозу: пожилые людей, беременные женщин, новорожденные и люди с ослабленной иммунной системой (со снженным иммунитетом). Риск повышается, если человек страдает такими заболеваниями, как СПИД, рак, болезни почек, сахарный диабет, или принимает некоторые лекарственные препараты. Инфекция чаще всего встречается у детей младше одного месяца и взрослых старше 60 лет. Беременные женщины составляют 27% случаев диагностированного листериоза, а лица с нарушенным иммунитетом -70% . У лиц с СПИДом в 280 раз больше шансов заболеть листериозом, чем у других.
Листерии могут паразитировать в животных и птицах, они так же найдены в почве, воде, канализации, а также в корме для животных. У 5 из 100 обследуемых людей в кишечнике выявляют листерий. Листериоз считается болезнью пищевого происхождения, потому что большинство людей, вероятно, заражаются после приема пищи, обсемененной листериями. Тем не менее, женщина может передать бактерии ребенку во время беременности. Кроме того, было несколько случаев, когда работники соответствующих профессий заражались листериозом, касаясь инфицированных телят и птицы.
Лица с особым риском по листериозу: пожилые людей, беременные женщин, новорожденные и люди с ослабленной иммунной системой (со снженным иммунитетом). Риск повышается, если человек страдает такими заболеваниями, как СПИД, рак, болезни почек, сахарный диабет, или принимает некоторые лекарственные препараты. Инфекция чаще всего встречается у детей младше одного месяца и взрослых старше 60 лет. Беременные женщины составляют 27% случаев диагностированного листериоза, а лица с нарушенным иммунитетом -70% . У лиц с СПИДом в 280 раз больше шансов заболеть листериозом, чем у других.
Клиническая картина
После того как люди потребляют в пищу продукты, загрязненные этой бактерии, симптомы проявляются через 11-70 дней. Большинство людей не отмечают каких-либо выраженных симптомов. Листерии могут вызвать расстройство желудка и кишечника. У лиц с листериозом может развиться гриппоподобные симптомы, такие как лихорадка, головная боль, тошнота и рвота, усталость, понос.
Беременные женщины испытывают умеренную лихорадку, боли в мышцах, расстройство желудка, кишечные проблемы. Инфекция может вызвать выкидыш, преждевременные роды, ранний разрыв плодного пузыря, мертворождение. Половина новорожденных, инфицированых листериями, умирают от этой болезни.
Есть два типа листериоза у новорожденного ребенка: с ранним и поздним началом болезни. Листериоз с ранним началом является серьезным заболеванием, которое возникает при рождении и обычно вызывает преждевременные роды. У младенцев, инфицированных во время беременности, как правило, возникает заражение крови (сепсис). Когда доношенный ребенок заражается листериями во время родов, заболевание проявляется поздним началом. Как правило, симптомы при этом появляются примерно через две недели после рождения. Дети с поздней формой заболевания обычно имеют менингит (воспаление головного и спинного тканей), однако они имеют больше шансов выжить, чем те дети, у которых симптомы диагностировалисьсразу после рождения.
Пациенты, заболевшие листериозом на фоне иммунодефицита, подвержены риску серьезных инфекций крови и центральной нервной системы (головного и спинного мозга). Менингит возникает примерно в половине случаев листериоза у взрослых. Симптомы листериозного менингита развиваются примерно через четыре дня после катаральных явлений и включают лихорадку, несогласованные движения мышц, тремор, мышечные сокращения, судороги.
Листерии вызывают эндокардит примерно в 7,5 процента случаев. Эндокардит это воспаление тканей сердца из-за бактериальной инфекции. Листериозный эндокардит является причиной смерти примерно у половины больных. Листериоз также может проявляться в виде абсцесса мозга, глазной инфекции, гепатита, перитонита, легочной инфекции, ко-инфекции, артрита, болезней сердца, инфекции костей, инфекциижелчного пузыря.
Ассоциированные симптомы: Кашель. Моноцитоз. Понос (диарея). Рвота. Рвота беременных.
Беременные женщины испытывают умеренную лихорадку, боли в мышцах, расстройство желудка, кишечные проблемы. Инфекция может вызвать выкидыш, преждевременные роды, ранний разрыв плодного пузыря, мертворождение. Половина новорожденных, инфицированых листериями, умирают от этой болезни.
Есть два типа листериоза у новорожденного ребенка: с ранним и поздним началом болезни. Листериоз с ранним началом является серьезным заболеванием, которое возникает при рождении и обычно вызывает преждевременные роды. У младенцев, инфицированных во время беременности, как правило, возникает заражение крови (сепсис). Когда доношенный ребенок заражается листериями во время родов, заболевание проявляется поздним началом. Как правило, симптомы при этом появляются примерно через две недели после рождения. Дети с поздней формой заболевания обычно имеют менингит (воспаление головного и спинного тканей), однако они имеют больше шансов выжить, чем те дети, у которых симптомы диагностировалисьсразу после рождения.
Пациенты, заболевшие листериозом на фоне иммунодефицита, подвержены риску серьезных инфекций крови и центральной нервной системы (головного и спинного мозга). Менингит возникает примерно в половине случаев листериоза у взрослых. Симптомы листериозного менингита развиваются примерно через четыре дня после катаральных явлений и включают лихорадку, несогласованные движения мышц, тремор, мышечные сокращения, судороги.
Листерии вызывают эндокардит примерно в 7,5 процента случаев. Эндокардит это воспаление тканей сердца из-за бактериальной инфекции. Листериозный эндокардит является причиной смерти примерно у половины больных. Листериоз также может проявляться в виде абсцесса мозга, глазной инфекции, гепатита, перитонита, легочной инфекции, ко-инфекции, артрита, болезней сердца, инфекции костей, инфекциижелчного пузыря.
Ассоциированные симптомы: Кашель. Моноцитоз. Понос (диарея). Рвота. Рвота беременных.
Причины
Человек заражается листериями при употреблении в пищу зараженных продуктов питания. Listeria была найдена на сырых овощах, в рыбе, птице, сыром (непастеризованном) молоке, свежем мясе, обработанном мясе (например, сосиски и мясные консервы), и в некоторых мягких сырах. Нередко вспышки листериозасвязаны с такими продуктами, как капуста, молоко, сыр, недоваренный хот-дог, колбасные продукты. В отличие от большинства других бактерий, листерии не перестают расти, если еда находится в холодильнике, их рост лишь немного замедлился. К счастью, соответствующаятемпература приготовления и пастеризации убивает эти бактерии.
Листерии могут проникнуть через стенку кишечника, и оттуда - в кровь. Попав в кровь, они могут транспортироваться в любой орган и часть тела, но обычно эти бактерии тропны к тканям центральной нервной системы (головного и спинного мозга). У беременных женщин они часто встречаются в плаценте. Листерий локализуются внутри белых кровяных клеток крови, которые называются макрофагами. Внутри макрофагов бактерии могут прятаться от иммунной реакции и становятся недоступными для некоторых антибиотиков. Они способны размножаться в макрофагах, распространяясь от одной клетки к другой.
Листерии могут проникнуть через стенку кишечника, и оттуда - в кровь. Попав в кровь, они могут транспортироваться в любой орган и часть тела, но обычно эти бактерии тропны к тканям центральной нервной системы (головного и спинного мозга). У беременных женщин они часто встречаются в плаценте. Листерий локализуются внутри белых кровяных клеток крови, которые называются макрофагами. Внутри макрофагов бактерии могут прятаться от иммунной реакции и становятся недоступными для некоторых антибиотиков. Они способны размножаться в макрофагах, распространяясь от одной клетки к другой.
Лечение
Листериоз является показанием для назначения антибиотиков (ампициллин) или сульфаметоксазол-триметоприма (Бактрим, Septra). Так как бактерии живут внутри макрофагов, лечение может быть затруднено, а сроки лечения могут варьировать. Как правило, беременные женщины лечатся в течение двух недель; новорожденные -2-3 недели; взрослые с легкой формой заболевания - 2-4 недели; при развитии менингита срок лечения составляет около 3-х недель, при абсцессах мозга терапия проводится сроком 5 недель, а лица с эндокардитом лечатся около 6 недель.
Пациенты должны быть госпитализированы для лечения и мониторинга. Другие препараты могут быть использованы для облегчения боли и лихорадки.
Общий коэффициент смертности при листериозе составляет 26 %. Такая высокая смертность связана с широкой распространенностью заболевания среди новорожденных, пожилых людей, и у ослабленных лиц с иммунодефицитом. Осложнения листериоза включают в себя: менингит, сепсис, выкидыши, мертворождения, пневмония, эндокардит, шок, абсцессы различной локализации.
Пациенты должны быть госпитализированы для лечения и мониторинга. Другие препараты могут быть использованы для облегчения боли и лихорадки.
Общий коэффициент смертности при листериозе составляет 26 %. Такая высокая смертность связана с широкой распространенностью заболевания среди новорожденных, пожилых людей, и у ослабленных лиц с иммунодефицитом. Осложнения листериоза включают в себя: менингит, сепсис, выкидыши, мертворождения, пневмония, эндокардит, шок, абсцессы различной локализации.
Профилактика
Для профилактики листериоза необходимо применять соответствующие меры. Лица свысоким риском (беременные женщины, лица с нарушенным иммунитетом, ) должны проявлять особую осторожность. Людям высокого риска следует избегать мягких сыров, таких как мексиканский сыр, фета, бри, камамбер и голубые сыры (творогом является безопасным); подвергать пищу тщательной кулинарной обработке, избегать покупки готовых блюд в магазинах.
Для всех людей риск заболетьлистериозом может быть уменьшен путем принятия следующих мер предосторожности:
- тщательно обрабатывать блюда из мяса и яиц;
- тщательно мыть сырые овощи перед едой;
- хранить сырое мясо отдельно от сырых овощей и готовых продуктов. После разделки сырого мяса, мыть разделочную доску с моющим средством перед использованием его для овощей.
- не пить непастеризованное молоко или продукты, сделанные из такого молока;
- тщательно мыть руки после контакта с сырым мясом;
-соблюдать сроки годности и условия хранения для определенной пищи.
Для всех людей риск заболетьлистериозом может быть уменьшен путем принятия следующих мер предосторожности:
- тщательно обрабатывать блюда из мяса и яиц;
- тщательно мыть сырые овощи перед едой;
- хранить сырое мясо отдельно от сырых овощей и готовых продуктов. После разделки сырого мяса, мыть разделочную доску с моющим средством перед использованием его для овощей.
- не пить непастеризованное молоко или продукты, сделанные из такого молока;
- тщательно мыть руки после контакта с сырым мясом;
-соблюдать сроки годности и условия хранения для определенной пищи.
|
|